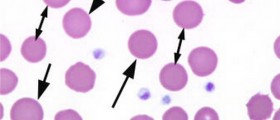

The most often anemia is light or mild anemia. There is also anemia caused by chronic diseases. Anemia in general limits transport of oxygen in blood, leveling down physical capacity and physical endurance of the body. Lowered ability to absorb oxygen from the lungs causes reduction in red blood cells, and may strike with severe health problem of prolonged anemia. Second step may be heart arrhythmia or heart failure or secondary dysfunction of organ. Of course, there are several inherited forms of anemia that may be fatal: sickle-cell anemia, pernicious anemia, thalassemia major.
Anemia occurs if there is not enough iron to produce hemoglobin. There are 3 phases caused by lack of iron in body and lead to actual anemia.
1) If there is not enough supply of iron that may lead to exhaustion of iron in bone marrow. The phase has no symptoms.
2) Second phase is if deficiencies of iron start to have affected on the production of hemoglobin when the hematocrit and hemoglobin are too low.
3) When production of hemoglobin falls down anemia may develop. Men need 1mg and women during the period 2mg of iron per day. Diets with not enough iron develop anemia. Also, blood loss may cause deficiency of iron.
And these are conditions serious or less serious caused by internal blood loss, conditions such as:
Esophageal cancer, colon or stomachHemorrhoidsSurgeriesa) Pica, Like celiac disease or inflammatory boweldisease. Anemia may cause bad pregnancy.Anemia affects badly on elderly people because levels down the strength, even mild anemia may cause cognitive impairment. Anemia may be fatal with cancer patientsSome type of anemia need often blood transfusions that may cause overload of iron.

Your thoughts on this
Loading...